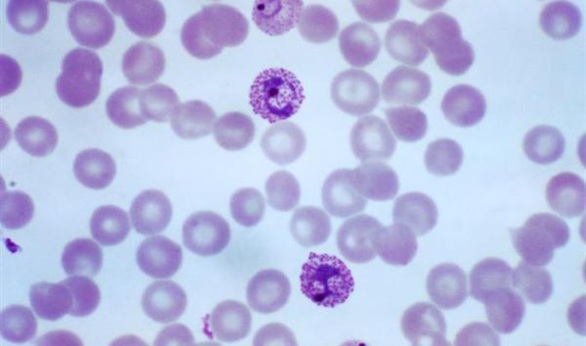

غدا.. المؤتمر العلمي الدولي السادس لعلم الطفيليات بدمنهور
تنظم كلية الطب البيطري بجامعة دمنهور غدا الثلاثاء فاعليات المؤتمر العلمي السادس للجمعية الطبية البيطرية المصرية لعلم الطفيليات في الفترة من 16 وحتى 18 ديسمبر الجاري بحضور اللواء مصطفى هدهود محافظ البحيرة، والدكتور سامي طه النقيب العام للأطباء البيطريين، ولفيف من الأساتذة والباحثين المتخصصين في مجال الطفيليات وكليات الطب البيطري بالجامعات المصرية وشركات الدواء البيطرية.
وقال الدكتور حاتم صلاح الدين رئيس جامعة دمنهور إن المؤتمر يقام على مدار 3 أيام يتم خلالها عرض أحدث ما وصلت إليه الأبحاث العلمية الحديثة في مجال الطفيليات والأمراض البيطرية من خلال مناقشة أمراض الدواجن وأهميتها الاقتصادية، والجودة ونظم ضمانها فى التعليم البيطرى واثره فى مجال تنمية الثروة الحيوانية ، ونبذة عن الحياة البرية فى مصر والإمكانيات المتاحة للاستغلال الأمثل لها، ودور الجامعات من خلال واقع المسئولية المجتمعية ودورها فى خدمة المجتمع.
يحاضر بالمؤتمر نخبة من الباحثين والمتخصصين في مجال الطب البيطري والطفيليات على مستوى الجامعات المصرية ومديريات الطب البيطري ومعاهد بحوث صحة الحيوان.






















